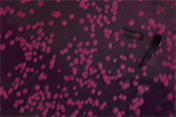

阴道分泌物增多、黄绿色、泡沫状、有臭味,阴道口外阴瘙痒,合并尿道感染,尿频、尿急、尿痛、尿血等。
外阴瘙痒、灼痛,白带增多呈豆腐渣样。阴道水肿、红斑、白色膜状。尿频、尿痛,性交痛等。

10%~40%患者无临床症状,有症状主要为阴道分泌物增多,鱼腥味,性交后加重,伴有轻度外阴瘙痒或灼热感。

急性期间全身乏力,下腹部坠胀不适,阴道分泌物增多,呈脓性,浆液性或血性,阴道有灼痛感,阴道黏膜充血。

阴道分泌物增多、呈淡黄色,严重呈脓血性白带,有臭味。外阴瘙痒或灼热感。合并尿道炎尿频、尿急、尿痛等。
该技术实现了致病菌的分型检测、精确定性、针对治疗,在不破坏女性正常生殖组织的情况下,采用外阴理疗、中药冲洗、多种药物个性化辅助调节,配合光谱、水循环微波进行立体式全方位治疗,全面有效地杀灭致病菌,修复受损表皮细胞。
采用高分辨率影象检查器械,清晰观察外阴部位的病变,准确定性,做到快诊断、快治疗。
利用微波、多功能光谱治疗仪的光热效应,使其细胞蛋白质凝固、坏死、脱落,再修复创面,促进新陈代谢,增强免疫。
将特制中药方剂经离子雾化器直送病灶,清热、祛湿、解毒,促进血液循环,增强免疫力,控制炎症。
全面调理,增强免疫力,巩固治疗效果,并对生活、饮食、精神等进行调理,消除诱因素,杜绝炎症交叉感染。